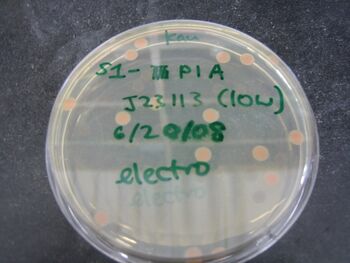
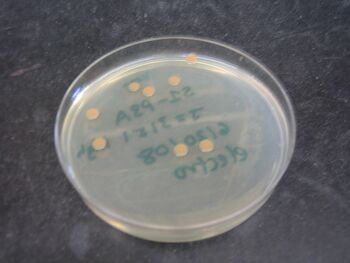
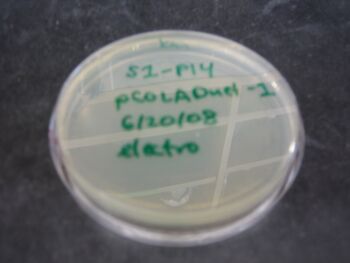
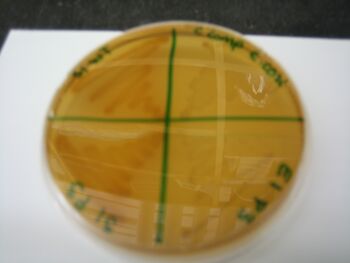

IGEM:Harvard/2008/Lab Notebooks/Image dump: Difference between revisions
From OpenWetWare
Jump to navigationJump to search
Meng Xiao He (talk | contribs) No edit summary |
|||
| Line 1: | Line 1: | ||
==Please remove the link to your image after you've put it in the appropriate place on the wiki.== | ==Please remove the link to your image after you've put it in the appropriate place on the wiki.== | ||
[[Image:7-23-08_analyticaldigA.jpg]] | |||
[[Image:7-11_digest_gel_2_TAMXH.jpg]] | [[Image:7-11_digest_gel_2_TAMXH.jpg]] | ||
[[Image:7-1_digest_Biobrick_Parts.jpg|350px]] | [[Image:7-1_digest_Biobrick_Parts.jpg|350px]] | ||